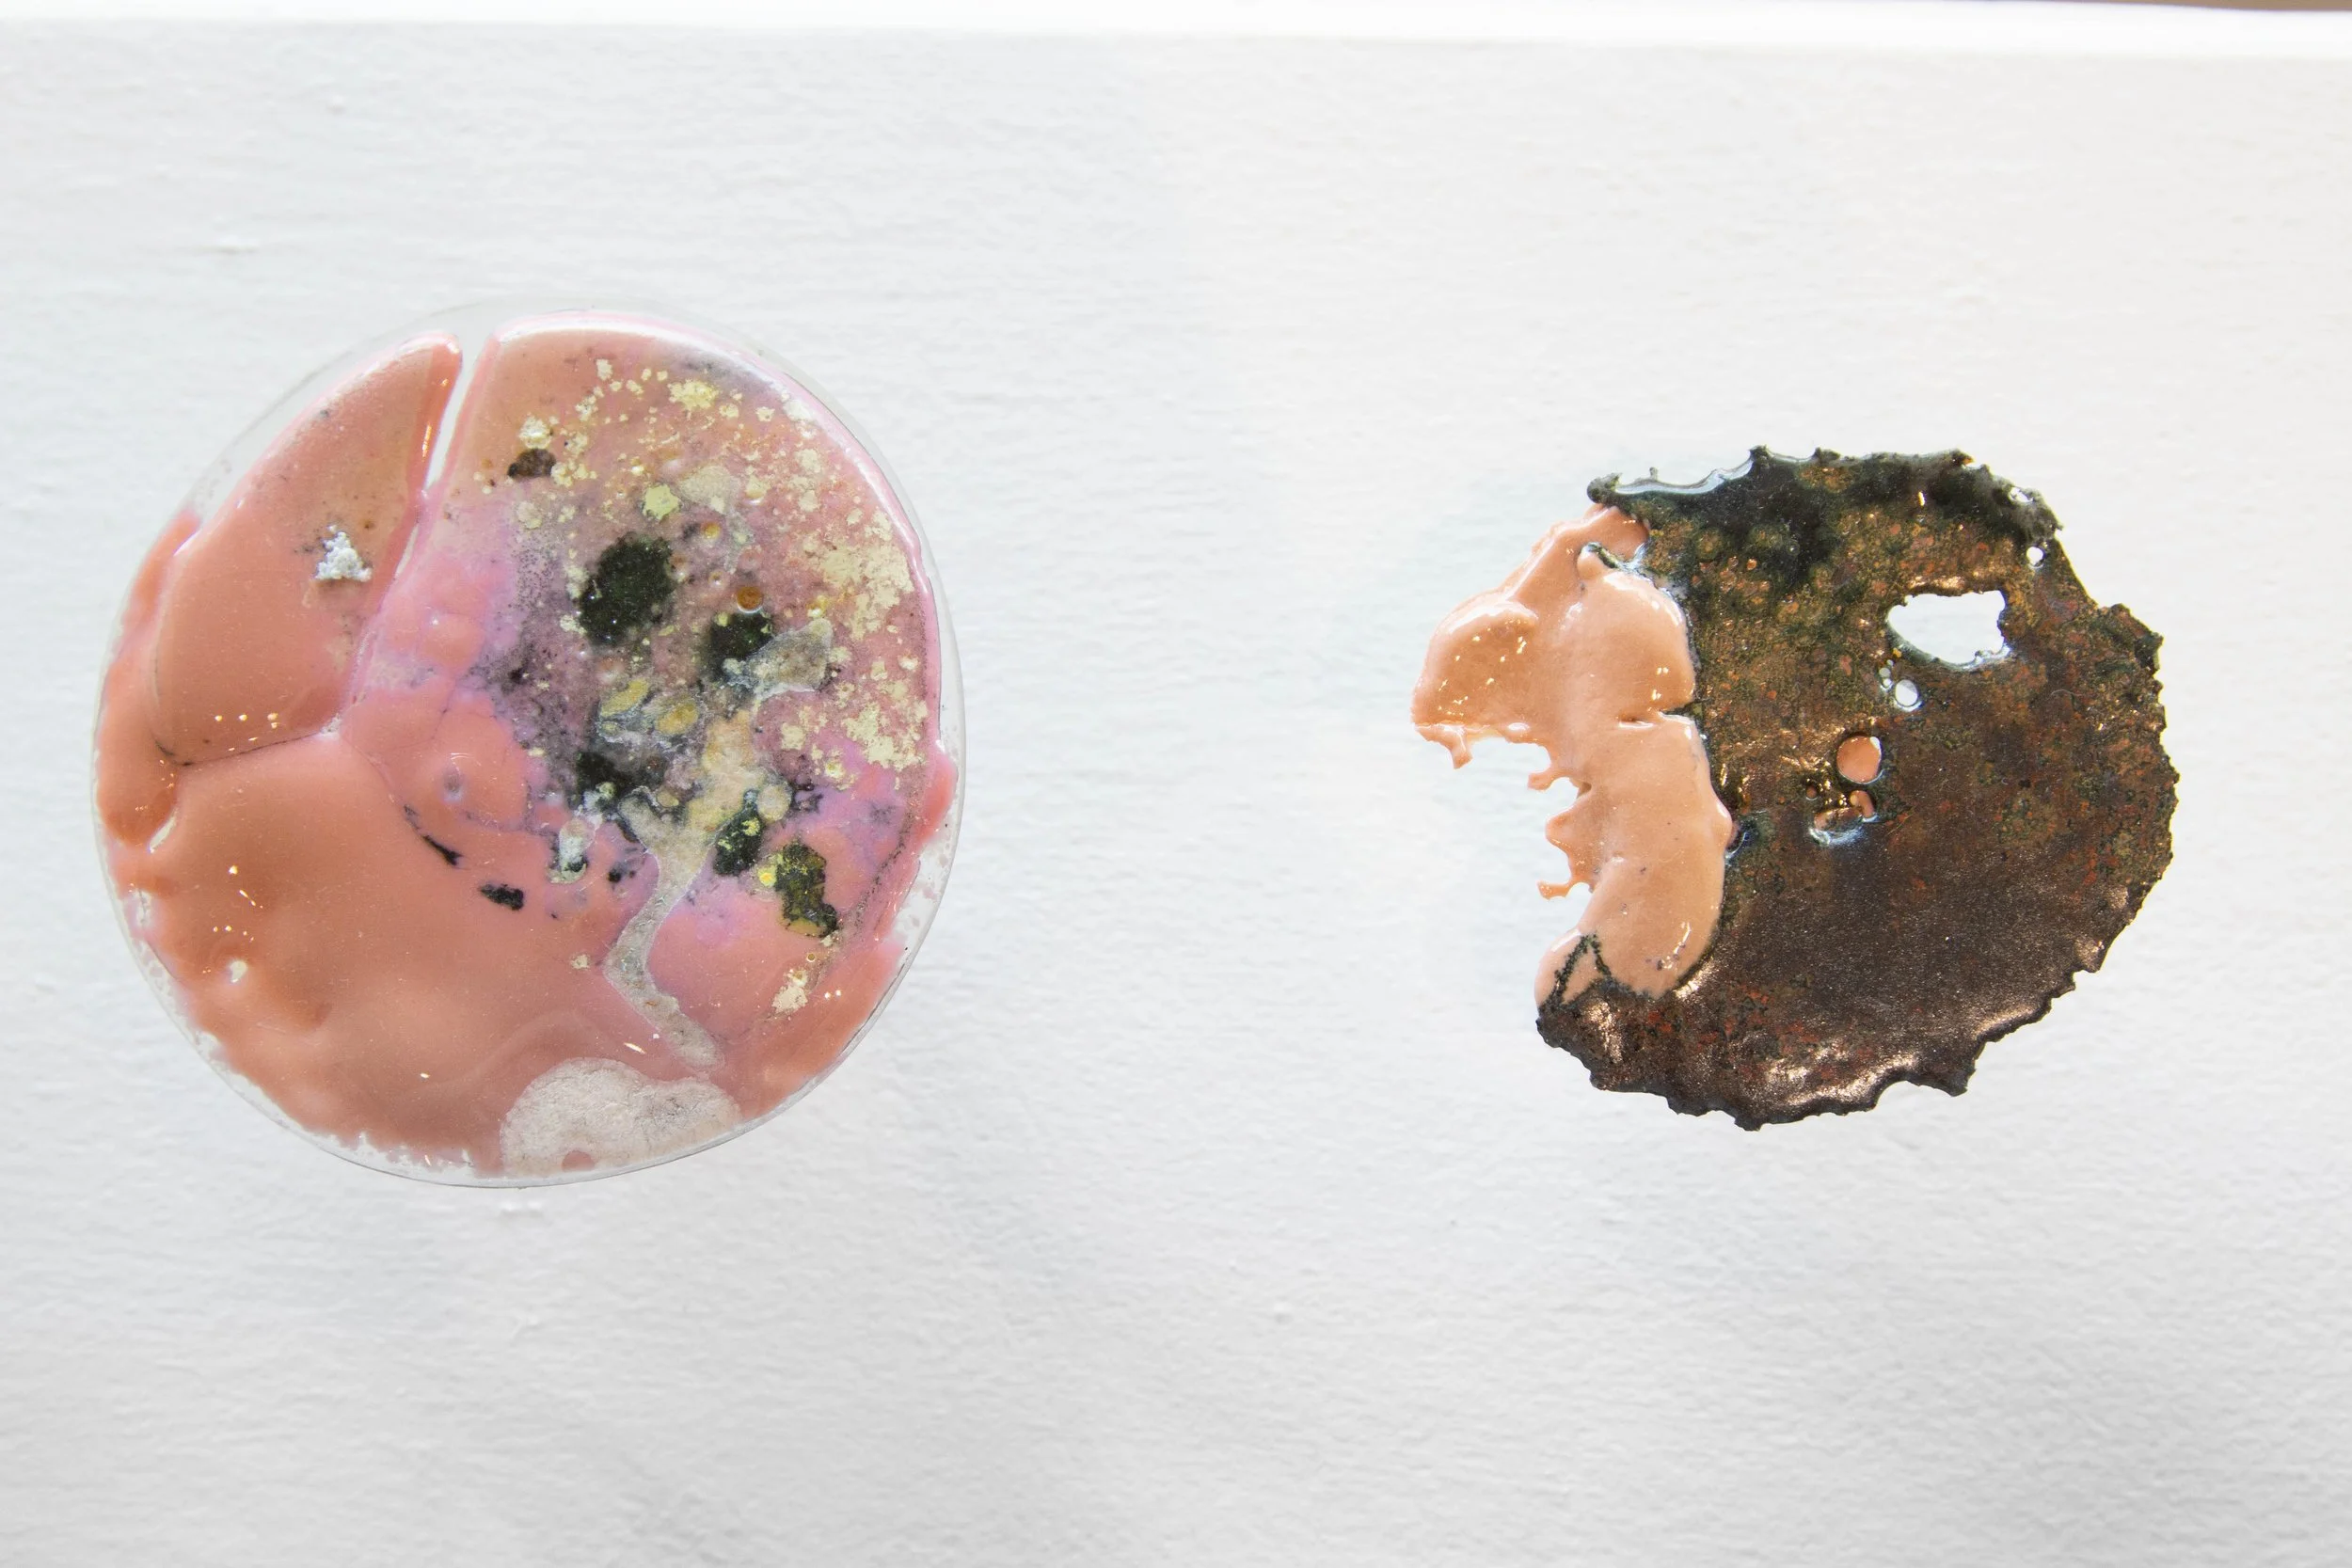
SHOP_LINDSYMARSHALL_INVESTIGATION TABLE DETAILS.jpg

Investigation Table by Lindsy Marshall
Investigation Table by Lindsy Marshall
Investigation Table is a multi-part sculpture where the artist has melted different glass powders, multiple binders such as gum Arabic and sodium silicate to create a fully textured different piece of glass. Marshall started this sculpture as a way to test her material, to become a scientist in a sense and create parameters for the glass to melt in and just see what happens. She is interested in understanding what different materials work together or against each other to see what is possible with a unique outcome.
Kiln formed glass
L 182.88 cm x W 30.48 cm x H 30.48 cm
2021
£350 per piece if sold individually
You can visit Lindsy’s page here to learn more about her and her work.
*Shipping price and Delivery Time might vary. We will notify you of the shipping cost as soon as you make your order.